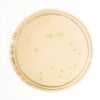

| Tên sản phẩm: | Lycorine chloride |
| Tên khác: | Alkaloids |
| CTHH: | C16H17NO4Cl |
| Code: | CFN99730 |
| CAS: | 2188-68-3 |
| Hàm lượng: | ≥98% |
| Hãng – xuất xứ: | ChemFaces – Trung Quốc |
| Ứng dụng: |
– Hóa chất được sử dụng trong phân tích, tổng hợp các chất hóa học tại phòng thí nghiệm trường học, viện nghiên cứu,… |
| Tính chất: |
– Dạng: bột màu trắng – Khối lượng mol: 323.78 g/mol |
| Bảo quản: | Lưu trữ dưới 30°C. |
| Quy cách đóng gói: | Chai thủy tinh 20mg |

Đánh giá
Chưa có đánh giá nào.